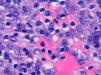

An 89-year-old female with no known relevant medical history presented with an asymptomatic, scaly, erythematous, infiltrated plaque on the scalp and part of the face. The lesion had appeared about a year earlier and had gradually grown to its size at the time of presentation (Fig. 1). The patient reported no systemic symptoms.
Physical ExaminationPhysical examination revealed a large, scaly, erythematous plaque on the left frontal and temporal region extending down to the left malar area and cheek. Areas of yellowish discoloration were observed in some parts of the lesion. Exophytic and keratotic lesions were present on the upper left side. There was no evidence of mucosal involvement and the patient's general condition was normal.
HistopathologyAt low magnification, a biopsy specimen from the edge of the lesion showed a slightly acanthotic and ulcerated but otherwise unremarkable epidermis as well as a granulomatous inflammatory infiltrate throughout the full thickness of the dermis and subcutaneous tissue. The granulomas had a lymphocytic corona (Fig. 2).
Higher magnification revealed basophilic dot-like structures in the cytoplasm of many histiocytes (Fig. 3) and Giemsa staining showed these structures to be cytoplasmic inclusion bodies without capsules.
What Is Your Diagnosis?
DiagnosisChronic cutaneous leishmaniasis.
Clinical CourseAdditional tests to rule out systemic involvement included a complete blood count, liver and kidney biochemistry, blood coagulation panel, chest radiograph, abdominal ultrasound, electrocardiogram, and serum anti–Leishmania immunoglobulins M and G, as well as urinary leishmanial antigen. Results were all normal or negative.
Further tests were carried out to rule out immune deficiency beyond that of advanced old age. Lymphocyte subpopulations, proteins, immunoglobulins, and serum immunofixation showed no significant abnormalities.
With a confirmed diagnosis of cutaneous leishmaniasis, the extent and degree of progression of the lesion as well as the patient's overall health status led to the choice of miltefosine therapy. Pending hospital authorization of this off-label treatment, the patient was started on intramuscular meglumine antimoniate, which had to be withdrawn when she developed signs of heart failure.
Ultimately, the patient and her family decided to forgo any further treatment. No clinical recurrence has been observed so far.
DiscussionLeishmaniasis is a zoonotic disease caused by a kinetoplastid protozoan of the Leishmania genus. This organism acts as an intracellular parasite of the mononuclear phagocytic system, and mammals are its reservoir hosts. In the Old World, leishmaniasis is transmitted by the bite of the female Phlebotomus sand fly. It is endemic to the Mediterranean basin. Clinical presentation may be cutaneous, mucocutaneous, or visceral. Manifestations vary according to the species involved (L infantum in the Mediterranean region) and to the patient's immune status prior to infection. Cutaneous signs range from the typical form, which consists of a centrally ulcerated papule, to extensive lesions or diffuse forms resulting from lymphatic or systemic spread.1,2
Extensive skin manifestations, such as the present case, may necessitate differential diagnosis with lupus vulgaris, cutaneous sarcoidosis, or granuloma faciale. Diagnosis is confirmed either by the presence of amastigotes (Leishman-Donovan bodies) in histiocyte cytoplasm or by polymerase chain reaction, used particularly in cases where few amastigotes are present.
These atypical, extensive cutaneous forms of leishmaniasis should be considered in immunodeficient as well as older patients. In recent years a number of cases of atypical cutaneous involvement have been described in patients undergoing treatment with anti–tumor necrosis factor biologic agents. Dermatologists should therefore consider the possibility of leishmaniasis in such cases even if clinical presentation does not otherwise suggest this diagnosis.3
New therapeutic options for leishmaniasis are now available,4,5 including topical treatments, such as imiquimod6 and photodynamic therapy, and some systemic therapies, such as miltefosine. Miltefosine is as effective as standard antimonial treatments and is less toxic.4,5
Conflicts of InterestThe authors declare that they have no conflicts of interest.
Please cite this article as: Torres Garcia Y, et al. Placa eritematodescamativa de lento crecimiento en la cara y el cuero cabelludo de una mujer anciana. Actas Dermosifiliogr. 2013;104:715–6.